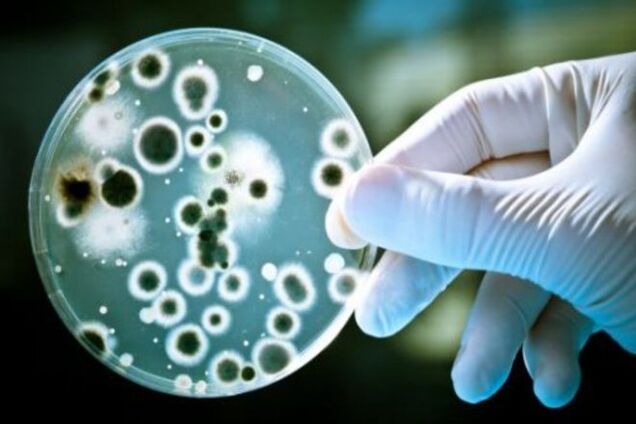
Біля узбережжя Ріо-де-Жанейро виявили супербактерію

Біля узбережжя Ріо-де-Жанейро виявили супербактерію
Дослідники виявили у водах, що омивають бразильське місто Ріо-де-Жанейро, фармакорезистентну бактерію.
Про це повідомляє ВВС.
Небезпечна супербактерія була знайдена поблизу пляжу Фламенго, у водах якого в 2016 році відбудуться змагання Олімпійських ігор з вітрильного спорту і віндсерфінгу.
Читайте: Вчені підрахували, скільки бактерій передається при поцілунку
Супербактерія зазвичай мешкає в смітті, яке викидають з лікарень, і виробляє ферменти, здатні протистояти антибіотикам, зазначає Бі-бі-сі.
За даними вчених, супербактерія може викликати сечову, шлунково-кишкову і легеневу інфекції.
"Враховуючи, що супербактерія стійка до найбільш сучасних препаратів, лікарі повинні будуть покластися на ліки, які використовуються дуже рідко, оскільки є токсичними для організму", - наводить Бі-бі-сі слова координатора клінічного дослідження в інституті Освальдо Круса.
Читайте: Знайдено новий спосіб, як дешевше злітати на Марс
Офіційні особи Бразилії, в свою чергу, стверджують, що розуміють стурбованість спортсменів, однак запевняють, що ніякої небезпеки немає.










